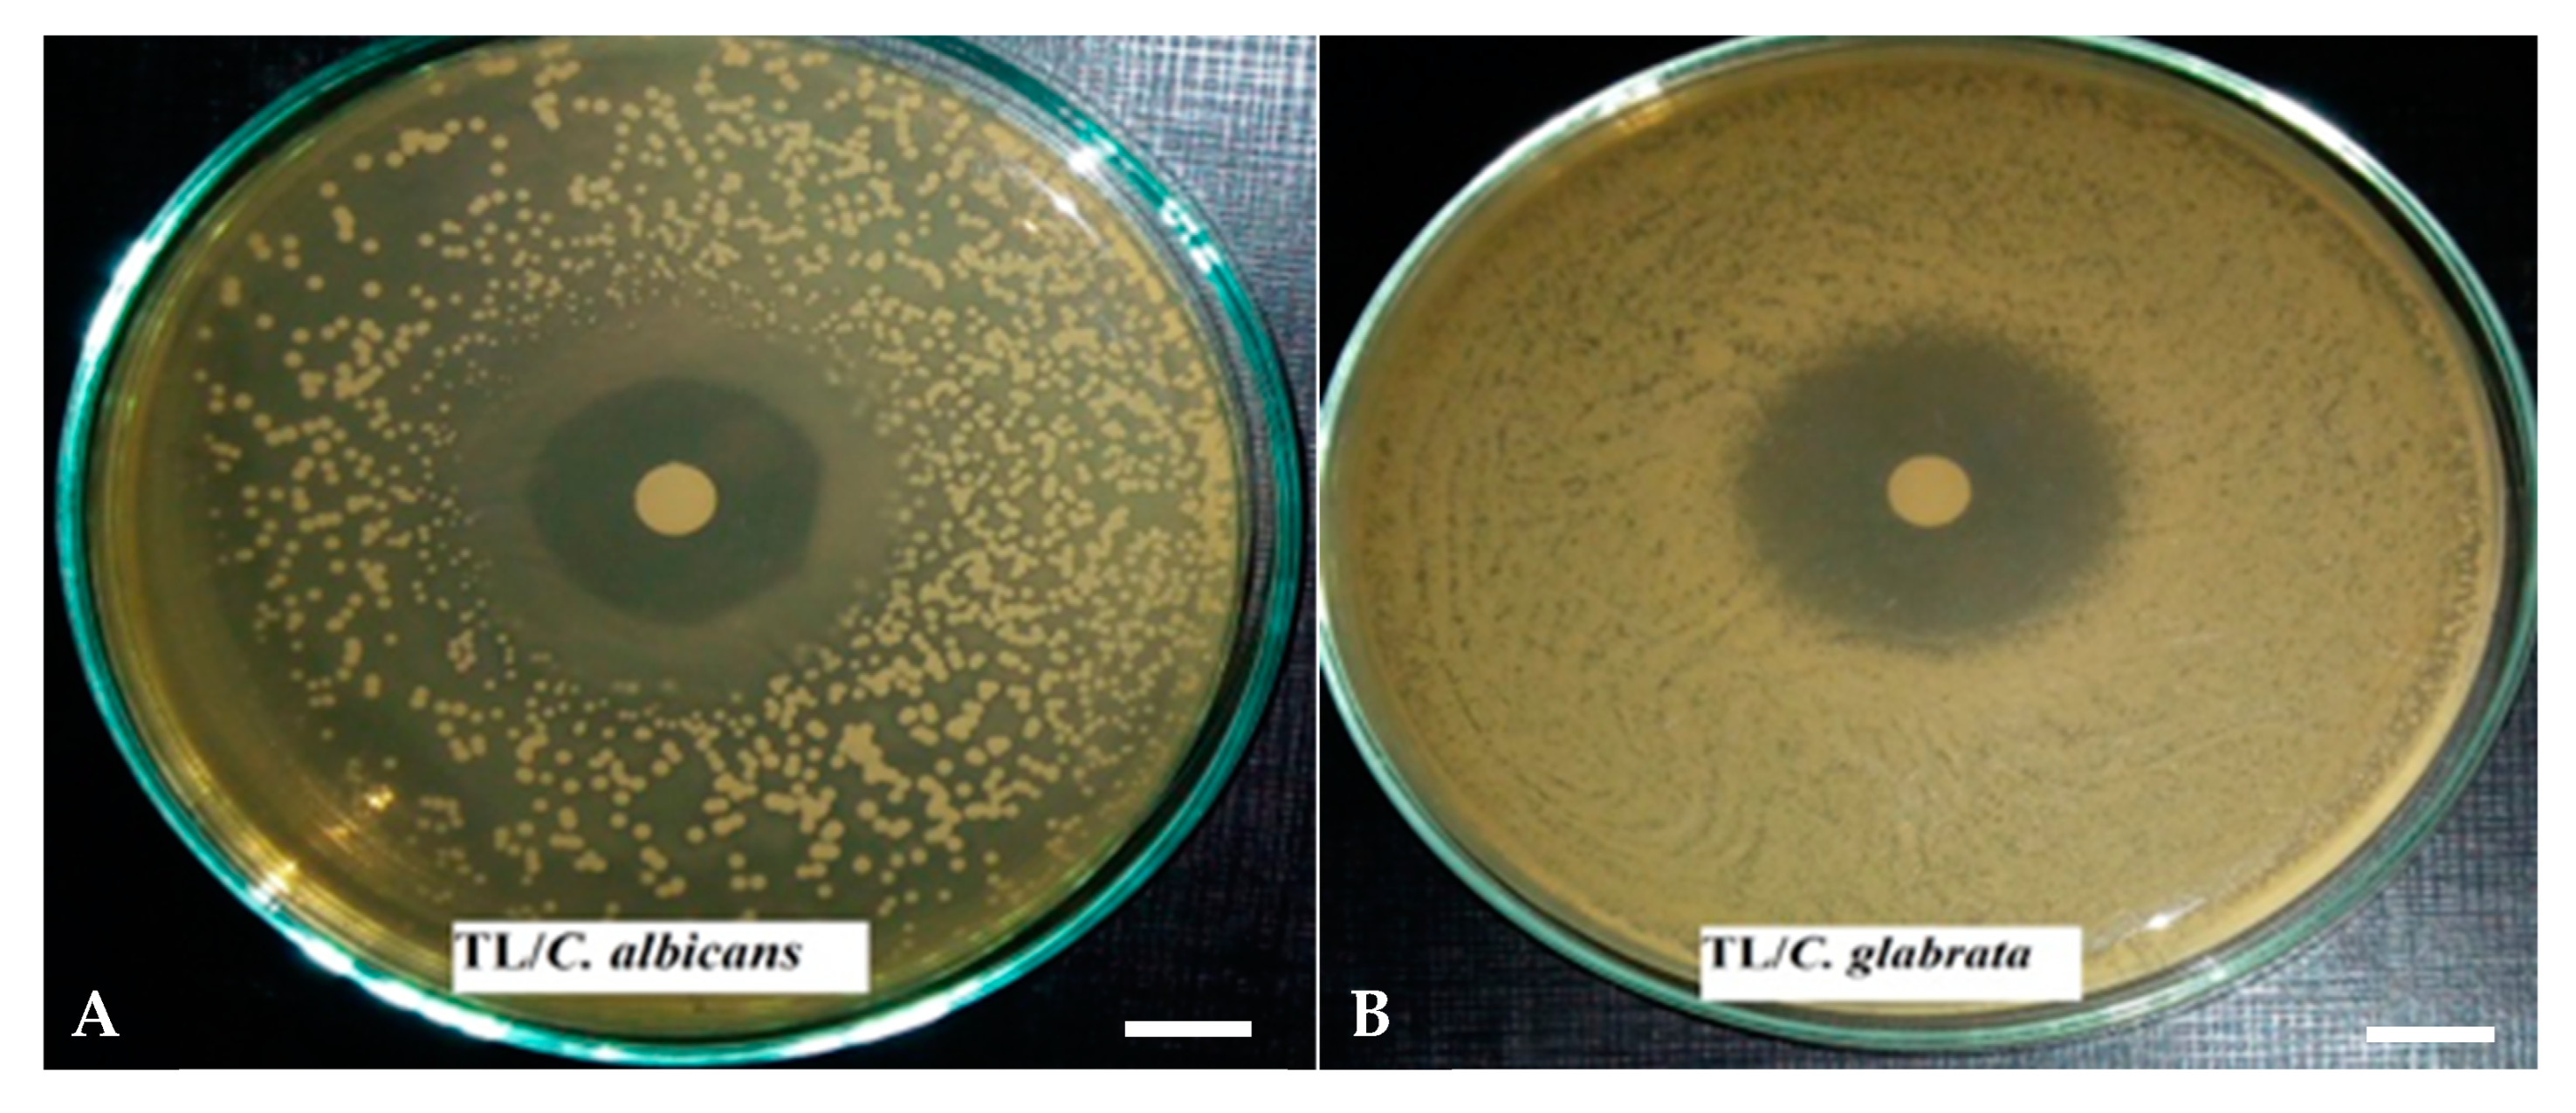
Pharmaceutics 14 01608 g001 550

Chemical Composition and Antimicrobial Activity of Essential Oils from Three Mediterranean Plants against Eighteen Pathogenic Bacteria and Fungi
Abstract
:1. Introduction
2. Materials and Methods
2.1. Chemicals
2.2. Plant Material
2.3. Extraction and Characterization of EOs
2.4. Antimicrobial Activity of EOs
2.4.1. Bacterial and Yeast Strains
2.4.2. Qualitative Analysis of Antimicrobial Activity: The Disc Diffusion Method
2.4.3. Quantitative Analysis of Antimicrobial Activity
- Determination of the minimum inhibitory concentration (MIC)
- 2.
- Determination of the minimum microbicidal concentration (MMC)
2.5. Data Collection and Statistical Analysis
3. Results and Discussion
3.1. EO Yield and Chemical Composition
3.2. Antifungal Activity of EOs
3.2.1. The Disk Diffusion Method
3.2.2. Determination of MIC and MMC Values
3.3. Antibacterial Activity of EOs
3.3.1. The Disk Diffusion Method
3.3.2. Determination of MIC and MMC Values
4. Conclusions
Author Contributions
Funding
Institutional Review Board Statement
Data Availability Statement
Conflicts of Interest
References
- Meziani, R.; Mazri, M.A.; Essarioui, A.; Alem, C.; Diria, G.; Gaboun, F.; El Idrissy, H.; Laaguidi, M.; Jaiti, F. Towards a new approach of controlling endophytic bacteria associated with date palm explants using essential oils, aqueous and methanolic extracts from medicinal and aromatic plants. Plant Cell Tissue Organ Cult. 2019, 137, 285–295. [Google Scholar] [CrossRef]
- Koufan, M.; Belkoura, I.; Mazri, M.A.; Amarraque, A.; Essatte, A.; Elhorri, H.; Zaddoug, F.; Alaoui, T. Determination of antioxidant activity, total phenolics and fatty acids in essential oils and other extracts from callus culture, seeds and leaves of Argania spinosa (L.) Skeels. Plant Cell Tissue Organ Cult. 2020, 141, 217–227. [Google Scholar] [CrossRef]
- Panda, H. Medicinal Plants Cultivation and Their Uses; Asia Pacific Business Press Inc.: Delhi, India, 2002. [Google Scholar]
- Gupta, A.; Atkinson, A.N.; Pandey, A.K.; Bishayee, A. Health-promoting and disease-mitigating potential of Verbascum thapsus L. (common mullein): A review. Phytother. Res. 2022, 36, 1507–1522. [Google Scholar] [CrossRef] [PubMed]
- Benkhnigue, O.; Ben Akka, F.; Salhi, S.; Fadli, M.; Douira, A.; Zidane, L. Catalogue des plantes médicinales utilisées dans le traitement du diabète dans la région d’Al Haouz-Rhamna (Maroc). J. Anim. Plant Sci. 2014, 23, 3539–3568. (In French) [Google Scholar]
- Ismaili, R.; Lanouari, S.; Lamiri, A.; Moustaid, K. Étude ethnobotanique de plantes aromatiques et médicinales Marocaines. Int. J. Innov. App. Stud. 2021, 34, 403–413. (In French) [Google Scholar]
- Asdadi, A.; Moutaj, R.; Hadek, M.E.; Hassani, L.M.I.; Chebli, B. Chemical polymorphism of populations of Thymus Leptobotrys L. harvested from the argan tree regions of Morocco, assessed by analysis of their essential oils, and its impact on their anticandidal and antioxidant activity. Int. J. Pharm. Sci. Invent. 2014, 3, 60–70. [Google Scholar]
- Caputo, L.; Nazzaro, F.; Souza, L.; De Martino, L.; Fratianni, F.; Coppola, R.; De Feo, V. Laurus nobilis: Composition of essential oil and its biological activities. Molecules 2017, 22, 930. [Google Scholar] [CrossRef]
- Vicidomini, C.; Roviello, V.; Roviello, G.N. Molecular Basis of the therapeutical potential of clove (Syzygium aromaticum L.) and clues to its anti-COVID-19 utility. Molecules 2021, 26, 1880. [Google Scholar] [CrossRef]
- Řebíčková, K.; Bajer, T.; Šilha, D.; Ventura, K.; Bajerová, P. Comparison of chemical composition and biological properties of essential oils obtained by hydrodistillation and steam distillation of Laurus nobilis L. Plant Foods Hum. Nutr. 2020, 75, 495–504. [Google Scholar] [CrossRef]
- Snuossi, M.; Trabelsi, N.; Ben Taleb, S.; Dehmeni, A.; Flamini, G.; de Feo, V. Laurus nobilis, Zingiber officinale and Anethum graveolens essential oils: Composition, antioxidant and antibacterial activities against bacteria isolated from fish and shellfish. Molecules 2016, 21, 1414. [Google Scholar] [CrossRef] [Green Version]
- Nafis, A.; Kasrati, A.; Jamali, C.A.; Custódio, L.; Vitalini, S.; Iriti, M.; Hassani, L. A comparative study of the in vitro antimicrobial and synergistic effect of essential oils from Laurus nobilis L. and Prunus armeniaca L. from Morocco with antimicrobial drugs: New approach for health promoting products. Antibiotics 2020, 9, 140. [Google Scholar] [CrossRef] [PubMed] [Green Version]
- Tomar, O.; Akarca, G.; Gök, V.; Ramadan, M.F. Composition and antibacterial effects of Laurel (Laurus nobilis L.) leaves essential oil. J. Essent. Oil Bear. Plants 2020, 23, 414–421. [Google Scholar] [CrossRef]
- Derwich, E.; Benziane, Z.; Boukir, A. Chemical composition and antibacterial activity of leaves essential oil of Laurus nobilis from Morocco. Aust. J. Basic Appl. Sci. 2009, 3, 3818–3824. [Google Scholar]
- Ben Jemâa, J.M.; Tersim, N.; Toudert, K.T.; Khouja, M.L. Insecticidal activities of essential oils from leaves of Laurus nobilis L. from Tunisia, Algeria and Morocco, and comparative chemical composition. J. Stored Prod. Res. 2012, 48, 97–104. [Google Scholar] [CrossRef]
- Ekren, S.; Yerlikaya, O.; Tokul, H.E.; Akpınar, A.; Accedil, M. Chemical composition, antimicrobial activity and antioxidant capacity of some medicinal and aromatic plant extracts. Afr. J. Microbiol. Res. 2013, 7, 383–388. [Google Scholar] [CrossRef] [Green Version]
- El Yaagoubi, M.; Mechqoq, H.; El Hamdaoui, A.; Jrv-Mukku, V.; El-Mousadik, A.; Msanda, F.; El Aouad, N. A review on Moroccan Thymus species: Traditional uses, essential oils chemical composition and biological effects. J. Ethnopharmacol. 2021, 278, 114205. [Google Scholar] [CrossRef]
- Nikolić, M.; Glamočlija, J.; Ferreira, I.; Calhelha, R.C.; Fernandes, Â.; Marković, T.; Marković, D.; Giweli, A.; Soković, M. Chemical composition, antimicrobial, antioxidant and antitumor activity of Thymus serpyllum L., Thymus algeriensis Boiss. and Reut and Thymus vulgaris L. essential oils. Ind. Crops Prod. 2014, 52, 183–190. [Google Scholar] [CrossRef]
- Bellakhdar, J. Medicinal Plants in North Africa and Basic Care. Handbook of Modern Herbal Medicine; Le Fennec: Casablanca, Morocco, 2006. [Google Scholar]
- Jamali, C.A.; El Bouzidi, L.; Bekkouche, K.; Lahcen, H.; Markouk, M.; Wohlmuth, H.; Leach, D.; Abbad, A. Chemical composition and antioxidant and anticandidal activities of essential oils from different wild Moroccan Thymus species. Chem. Biodivers. 2012, 9, 1188–1197. [Google Scholar] [CrossRef]
- Boubaker, H.; Karim, H.; El Hamdaoui, A.; Msanda, F.; Leach, D.; Bombarda, I.; Vanloot, P.; Abbad, A.; Boudyach, E.H.; Ait Ben Aoumar, A. Chemical characterization and antifungal activities of four Thymus species essential oils against postharvest fungal pathogens of citrus. Ind. Crop. Prod. 2016, 86, 95–101. [Google Scholar] [CrossRef]
- Jamali, C.A.; Kastrati, A.; Bekkouche, K.; Hassani, L.; Wohlmuth, H.; Leach, D.; Abbad, A. Cultivation and the application of inorganic fertilizer modifies essential oil composition in two Moroccan species of Thymus. Ind. Crops Prod. 2014, 62, 113–118. [Google Scholar] [CrossRef]
- Oubihi, A.; Ouryemchi, I.; Nounah, I.; Tarfaoui, K.; Harhar, H.; Ouhssine, M.; Guessous, Z. Chemical composition, antibacterial and antifungal activities of Thymus leptobotrys Murb essential oil. Adv. Tradit. Med. 2020, 20, 673–679. [Google Scholar] [CrossRef]
- Oubihi, A.; Hosni, H.; Nounah, I.; Ettouil, E.; Harhar, H.; Alaoui, K.; Ouhssine, M.; Guessous, Z. Phenolic content, antioxidant activity, anti-inflammatory potential, and acute toxicity study of Thymus leptobotrys Murb. Extracts. Biochem. Res. Int. 2020, 2020, 8823209. [Google Scholar] [CrossRef] [PubMed]
- Imane, N.I.; Fouzia, H.; Azzahra, L.F.; Ahmed, E.; Ismail, G.; Idrissa, D.; Mohamed, K.H.; Sirine, F.; L’Houcine, O.; Noureddine, B. Chemical composition, antibacterial and antioxidant activities of some essential oils against multidrug resistant bacteria. Eur. J. Integr. Med. 2020, 35, 101074. [Google Scholar] [CrossRef]
- Selles, S.M.A.; Kouidri, M.; Belhamiti, B.T.; Amrane, A.A. Chemical composition, in-vitro antibacterial and antioxidant activities of Syzygium aromaticum essential oil. J. Food Meas. Charact. 2020, 14, 2352–2358. [Google Scholar] [CrossRef]
- Rana, I.S.; Rana, A.S.; Rajak, R.C. Evaluation of antifungal activity in essential oil of the Syzygium aromaticum (L.) by extraction, purification and analysis of its main component eugenol. Brazilian J. Microbiol. 2011, 42, 1269–1277. [Google Scholar] [CrossRef]
- Zhang, Y.; Wang, Y.; Zhu, X.; Cao, P.; Wei, S.; Lu, Y. Antibacterial and antibiofilm activities of eugenol from essential oil of Syzygium aromaticum (L.) Merr. & L. M. Perry (clove) leaf against periodontal pathogen Porphyromonas gingivalis. Microb. Pathog. 2017, 113, 396–402. [Google Scholar] [CrossRef]
- Lambert, M.M.; Campos, D.R.; Borges, D.A.; de Avelar, B.R.; Ferreira, T.P.; Cid, Y.P.; Boylan, F.; Scott, F.B.; de Almeida Chaves, D.S.; Coumendouros, K. Activity of Syzygium aromaticum essential oil and its main constituent eugenol in the inhibition of the development of Ctenocephalides felis felis and the control of adults. Vet. Parasitol. 2020, 282, 109126. [Google Scholar] [CrossRef]
- Fadli, M.; Pagès, J.M.; Mezrioui, N.E.; Abbad, A.; Hassani, L. Artemisia herba-alba Asso and Cymbopogon citratus (DC.) Stapf essential oils and their capability to restore antibiotics efficacy. Ind. Crops Prod. 2016, 89, 399–404. [Google Scholar] [CrossRef]
- Croxen, M.A.; Law, R.J.; Scholz, R.; Keeney, K.M.; Wlodarska, M.; Finlay, B.B. Recent advances in understanding enteric pathogenic Escherichia coli. Clin. Microbiol. Rev. 2013, 26, 822–880. [Google Scholar] [CrossRef] [Green Version]
- Garoy, E.Y.; Gebreab, Y.B.; Achila, O.O.; Tekeste, D.G.; Kesete, R.; Ghirmay, R.; Kiflay, R.; Tesfu, T. Methicillin-resistant Staphylococcus aureus (MRSA): Prevalence and antimicrobial sensitivity pattern among patients-a multicenter study in Asmara, Eritrea. Can. J. Infect. Dis. Med. Microbiol. 2019, 2019, 8321834. [Google Scholar] [CrossRef] [Green Version]
- Xiao, Z.; Wang, Q.; Zhu, F.; An, Y. Epidemiology, species distribution, antifungal susceptibility and mortality risk factors of candidemia among critically ill patients: A retrospective study from 2011 to 2017 in a teaching hospital in China. Antimicrob. Resist. Infect. Control 2019, 8, 89. [Google Scholar] [CrossRef] [PubMed]
- Abi-Said, D.; Anaissie, E.; Uzun, O.; Raad, I.; Pinzcowski, H.; Vartivarian, S. The epidemiology of hematogenous candidiasis caused by different Candida species. Clin. Infect. Dis. 1997, 24, 1122–1128. [Google Scholar] [CrossRef] [PubMed] [Green Version]
- Ponce, A.G.; Fritz, R.; Del Valle, C.; Roura, S.I. Antimicrobial activity of essential oils on the native microflora of organic Swiss chard. LWT Food Sci. Technol. 2003, 36, 679–684. [Google Scholar] [CrossRef]
- Jamali, C.A.; Kasrati, A.; Bekkouche, K.; Hassani, L.; Wohlmuth, H.; Leach, D.; Abbad, A. Phenological changes to the chemical composition and biological activity of the essential oil from Moroccan endemic thyme (Thymus maroccanus Ball). Ind. Crops Prod. 2013, 49, 366–372. [Google Scholar] [CrossRef]
- Guan, W.; Li, S.; Yan, R.; Tang, S.; Quan, C. Comparison of essential oils of clove buds extracted with supercritical carbon dioxide and other three traditional extraction methods. Food Chem. 2007, 101, 1558–1564. [Google Scholar] [CrossRef]
- Nana, W.L.; Eke, P.; Fokom, R.; Bakanrga-Via, I.; Begoude, D.; Tchana, T.; Tchameni, N.S.; Kuate, J.; Menut, C.; Boyom, F.F. Antimicrobial activity of Syzygium aromaticum and Zanthoxylum xanthoxyloides essential oils against Phytophthora megakarya. J. Phytopathol. 2015, 163, 632–641. [Google Scholar] [CrossRef]
- Dammak, I.; Hamdi, Z.; El Euch, S.K.; Zemni, H.; Mliki, A.; Hassouna, M.; Lasram, S. Evaluation of antifungal and anti-ochratoxigenic activities of Salvia officinalis, Lavandula dentata and Laurus nobilis essential oils and a major monoterpene constituent 1, 8-cineole against Aspergillus carbonarius. Ind. Crops Prod. 2019, 128, 85–93. [Google Scholar] [CrossRef]
- Taarabt, K.O.; Koussa, T.; Alfeddy, M.N. Caractéristiques physicochimiques et activité antimicrobienne de l’huile essentielle du Laurus Nobilis L. au Maroc. Afr. Sci. 2017, 13, 349–359. (In French) [Google Scholar]
- Abd Rashed, A.; Rahman, A.Z.A.; Rathi, D.N.G. Essential oils as a potential neuroprotective remedy for age-related neurodegenerative diseases: A review. Molecules 2021, 26, 1107. [Google Scholar] [CrossRef]
- Mondal, A.; Bose, S.; Mazumder, K.; Khanra, R. Carvacrol (Origanum vulgare): Therapeutic properties and molecular mechanisms. In Advanced Structured Materials; Pal, D., Nayak, A.K., Eds.; Springer Science and Business Media Deutschland GmbH: Berlin, Germany, 2021; pp. 437–462. [Google Scholar]
- Lim, W.; Ham, J.; Bazer, F.W.; Song, G. Carvacrol induces mitochondria-mediated apoptosis via disruption of calcium homeostasis in human choriocarcinoma cells. J. Cell. Physiol. 2019, 234, 1803–1815. [Google Scholar] [CrossRef]
- Wauton, I.; Ogbeide, S.E. Characterization of pyrolytic bio-oil from water hyacinth (Eichhornia crassipes) pyrolysis in a fixed bed reactor. Biofuels 2019, 12, 899–904. [Google Scholar] [CrossRef]
- Ulanowska, M.; Olas, B. Biological properties and prospects for the application of eugenol-A review. Int. J. Mol. Sci. 2021, 22, 3671. [Google Scholar] [CrossRef] [PubMed]
- Zari, A.T.; Zari, T.A.; Hakeem, K.R. Anticancer properties of eugenol: A review. Molecules 2021, 26, 7407. [Google Scholar] [CrossRef] [PubMed]
- Jeldi, L.; Ouled Taarabt, K.; Mazri, M.A.; Ouahmane, L.; Alfeddy, M.N. Chemical composition, antifungal and antioxidant activities of wild and cultivated Origanum compactum essential oils from the municipality of Chaoun, Morocco. South Afr. J. Bot. 2022, 147, 852–858. [Google Scholar] [CrossRef]
- Benchaar, C.; Greathead, H. Essential oils and opportunities to mitigate enteric methane emissions from ruminants. Anim. Feed Sci. Technol. 2011, 166–167, 338–355. [Google Scholar] [CrossRef]
- Marchese, A.; Arciola, C.R.; Barbieri, R.; Silva, A.S.; Nabavi, S.F.; Sokeng, A.J.T.; Izadi, M.; Jafari, N.J.; Suntar, I.; Daglia, M.; et al. Update on monoterpenes as antimicrobial agents: A particular focus on p-cymene. Materials 2017, 10, 947. [Google Scholar] [CrossRef] [PubMed]
- Riabov, P.A.; Micić, D.; Božović, R.B.; Jovanović, D.V.; Tomić, A.; Šovljanski, O.; Filip, S.; Tosti, T.; Ostojić, S.; Blagojević, S.; et al. The chemical, biological and thermal characteristics and gastronomical perspectives of Laurus nobilis essential oil from different geographical origin. Ind. Crop. Prod. 2020, 151, 112498. [Google Scholar] [CrossRef]
- Di Pasqua, R.; Betts, G.; Hoskins, N.; Edwards, M.; Ercolini, D.; Mauriello, G. Membrane toxicity of antimicrobial compounds from essential oils. J. Agric. Food Chem. 2007, 55, 4863–4870. [Google Scholar] [CrossRef]
- Nejad Ebrahimi, S.; Hadian, J.; Mirjalili, M.H.; Sonboli, A.; Yousefzadi, M. Essential oil composition and antibacterial activity of Thymus caramanicus at different phenological stages. Food Chem. 2008, 110, 927–931. [Google Scholar] [CrossRef]
- Beltrán-Villalobos, K.L.; Déciga-Campos, M.; Aguilar-Mariscal, H.; González-Trujano, M.E.; Martínez-Salazar, M.F.; Ramírez-Cisneros, M.; Rios, M.Y.; López-Muñoz, F.J. Synergistic antinociceptive interaction of Syzygium aromaticum or Rosmarinus officinalis coadministered with ketorolac in rats. Biomed. Pharmacother. 2017, 94, 858–864. [Google Scholar] [CrossRef]
- Mayaud, L.; Carricajo, A.; Zhiri, A.; Aubert, G. Comparison of bacteriostatic and bactericidal activity of 13 essential oils against strains with varying sensitivity to antibiotics. Lett. Appl. Microbial. 2008, 47, 167–173. [Google Scholar] [CrossRef] [PubMed]
- Harpaz, S.; Glatman, L.; Drabkin, V.; Gelman, A. Effects of herbal essential oils used to extend the shelf life of freshwater-reared asian sea bass fish (Lates calcarifer). J. Food Prot. 2003, 66, 410–417. [Google Scholar] [CrossRef] [PubMed]
- Mahboobi, M.; Shahcheraghi, F.; Feizabadi, M.M. Bactericidal effects of essential oils from clove, lavender and geranium on multi-drug resistant isolates of Pseudomonas aeruginosa. Iran. J. Biotechnol. 2006, 4, 137–140. [Google Scholar]
- El-Shouny, W.A.; Ali, S.S.; Sun, J.; Samy, S.M.; Ali, A. Drug resistance profile and molecular characterization of extended spectrum beta-lactamase (ESβL)-producing Pseudomonas aeruginosa isolated from burn wound infections. Essential oils and their potential for utilization. Microb. Pathog. 2018, 116, 301–312. [Google Scholar] [CrossRef]
| Compound | RI 1 | RT 2 | Content (%) | ||
|---|---|---|---|---|---|
| T. leptobotrys | L. nobilis | S. aromaticum | |||
| α-Pinene | 936 | 5.452 | 1.77 | 1.66 | - 3 |
| Sabinene | 975 | 6.183 | - | 4.08 | - |
| β-Pinene | 980 | 6.266 | - | 1.45 | - |
| Camphene | 998 | 5.740 | 1.55 | 12.94 | 0.21 |
| α-Terpinene | 1020 | 7.005 | 0.76 | - | - |
| ρ-Cymene | 1025 | 7.160 | 5.71 | - | - |
| γ-Terpinene | 1059 | 7.849 | 5.79 | - | - |
| 1,8-Cineole | 1069 | 7.323 | - | 31.48 | - |
| Linalool | 1099 | 8.659 | - | 12.13 | - |
| Camphor | 1168 | 9.665 | 2.10 | - | 0.29 |
| 4-Terpineol | 1179 | 10.316 | - | 1.32 | - |
| α-Terpineol | 1196 | 10.571 | - | 7.85 | - |
| Bornyl acetate | 1279 | 12.467 | - | 1.85 | - |
| Carvacrol | 1302 | 12.696 | 75.05 | - | - |
| Thymol | 1316 | 12.483 | 2.46 | - | - |
| Eugenol | 1358 | 13.819 | - | 5.05 | 82.16 |
| Trans-isoeugenol | 1406 | 15.515 | - | 1.88 | - |
| α-Gurjunene | 1407 | 16.408 | 1.12 | - | - |
| β-Elemene | 1417 | 14.517 | - | 1.61 | - |
| Caryophyllene | 1426 | 15.072 | 1.82 | - | 0.79 |
| Aromadendrene | 1445 | 15.423 | 1.13 | - | - |
| Trans-cinnamyl acetate | 1448 | 15.398 | - | 1.37 | - |
| Methyleugenol | 1499 | 14.650 | - | 9.61 | - |
| β-Bisabolene | 1511 | 16.554 | 0.73 | - | - |
| Acetyleugenol | 1521 | 16.855 | - | - | 16.55 |
| Trans-isoelemicin | 1568 | 18.909 | - | 1.69 | - |
| β-Eudesmol | 1635 | 19.051 | - | 0.89 | - |
| (rac)-1,3,6,8-Tetramethylcyclododeca-1,2,6,7-tetraene | 1670 | 19.510 | - | 3.14 | - |
| Yield (%, v/w) | 1.79 ± 0.06 | 1.81 ± 0.03 | 13.24 ± 0.01 | ||
| Microorganism | Diameter in mm 1 | ||||
|---|---|---|---|---|---|
| Essential Oils (2 µL/disc) | Positive Control (40 µg/disc) | Negative Control (2 µL/disc) | |||
| S. aromaticum | T. leptobotrys | L. nobilis | Fluconazole | DMSO | |
| C. albicans (CCMM L4) | 14.00 ± 1.00 d | 27.00 ± 1.00 g | 7.00 ± 0.00 a | 26.00 ± 1.00 f,g | NA 2 |
| C. glabrata (CCMM L7) | 24.67 ± 0.58 f | 30.67 ± 1.15 h | 10.33 ± 0.58 b | 21.33 ± 0.58 e | NA |
| C. krusei (CCMM L10) | 20.33 ± 0.58 e | 30.00 ± 1.00 h | 9.33 ± 0.58 b | 19.33 ± 0.58 e | NA |
| C. parapsilosis (CCMM L18) | 25.00 ± 0.00 f | 23.67 ± 0.58 f | 9.00 ± 0.00 b | 18.33 ± 0.58 e | NA |
| A. niger (CCMM M100) | 44.00 ± 1.00 i | 45.00 ± 1.00 i | 12.00 ± 0.00 c | 6.67 ± 0.58 a | NA |
| Microorganism | Essential Oils (mg/mL) | Positive Control (µg/mL) | |||
|---|---|---|---|---|---|
| Antimicrobial Activity | S. aromaticum | T. leptobotrys | L. nobilis | Fluconazole | |
| C. albicans (CCMM L4) | MIC | 5.00 ± 0.00 c | 1.25 ± 0.00 a | 20.00 ± 0.00 e | 0.24 ± 0.00 |
| MMC | 5.00 ± 0.00 χ | 1.25 ± 0.00 α | 20.00 ± 0.00 δ | 0.24 ± 0.00 | |
| C. glabrata (CCMM L7) | MIC | 2.50 ± 0.00 b | 1.25 ± 0.00 a | 40.00 ± 0.00 f | 0.24 ± 0.00 |
| MMC | 2.50 ± 0.00 β | 1.25 ± 0.00 α | 40.00 ± 0.00 ε | 0.24 ± 0.00 | |
| C. krusei (CCMM L10) | MIC | 1.25 ± 0.00 a | 1.25 ± 0.00 a | 40.00 ± 0.00 f | 0.24 ± 0.00 |
| MMC | 1.25 ± 0.00 α | 1.25 ± 0.00 α | 40.00 ± 0.00 ε | 0.24 ± 0.00 | |
| C. parapsilosis (CCMM L18) | MIC | 1.25 ± 0.00 a | 1.25 ± 0.00 a | 10.00 ± 0.00 d | 0.24 ± 0.00 |
| MMC | 2.50 ± 0.00 β | 1.25 ± 0.00 α | 20.00 ± 0.00 δ | 0.24 ± 0.00 | |
| A. niger (CCMM M100) | MIC | 1.25 ± 0.00 a | 0.625 ± 0.00 a | 40.00 ± 0.00 f | NA 1 |
| MMC | 1.25 ± 0.00 α | 0.625 ± 0.00 α | 40.00 ± 0.00 ε | NA | |
| Microorganism | Diameter in mm 1 | ||||
|---|---|---|---|---|---|
| Essential Oils (2 µL/disc) | Positive Control | Negative Control | |||
| S. aromaticum | T. leptobotrys | L. nobilis | Ciprofloxacin (15 µg/disc) | DMSO (2 µL/disc) | |
| Gram-negative bacteria | |||||
| E. coli (ATCC 35214) | 12.67 ± 1.15 d,e | 24.33 ± 3.05 h–j | 8.33 ± 0.58 a–c | 26.33 ± 2.30 j | NA 2 |
| E. coli (ATCC 8739) | 12.33 ± 0.58 c–e | 20.33 ± 0.58 f,g | 9.33 ± 0.58 a–d | 6.00 ± 0.00 a | NA |
| K. pneumoniae (CIP 104727) | 10.00 ± 1.00 a–d | 23.67 ± 0.58 g–j | 8.33 ± 0.58 a–c | 6.00 ± 0.00 a | NA |
| K. pneumoniae (clinical isolates) | 11.67 ± 0.58 b–d | 22.33 ± 0.58 g–i | 10.33 ± 0.58 a–d | 10.00 ± 0.00 a–d | NA |
| L. monocytogenes (ATCC 19115) | 15.00 ± 2.65 e | 21.67 ± 4.93 g,h | 8.00 ± 1.00 a,b | 6.00 ± 0.00 a | NA |
| S. enteritidis (DMB 560) | 11.33 ± 0.58 b–d | 25.33 ± 1.15 i,j | 9.67 ± 2.89 a–d | 24.67 ± 3.05 h–j | NA |
| P. aeruginosa (ATCC 27853) | 9.67 ± 0.58 a–d | 20.67 ± 1.52 f,g | 6.00 ± 0. 00 a | 11.67 ± 0.58 b–d | NA |
| P. aeruginosa (DSM 50090) | 6.33 ± 0.58 a | 7.00 ± 0.00 a | 6.00 ± 0.00 a | 10.17 ± 0.21 a–d | NA |
| Gram-positive bacteria | |||||
| S. aureus (ATCC 29213) | 11.67 ± 0.58 b–d | 24.33 ± 1.15 h–j | 7.67 ± 0.58 a,b | 22.67 ± 0.58 g–i | NA |
| S. aureus (209 PCIP 53156) | 21.67 ± 0.58 g,h | 36.67 ± 0.58 l | 32.33 ± 0.58 k | 13.97 ± 0.06 d,e | NA |
| B. cereus (ATCC 14579) | 9.67 ± 1.15 a–d | 22.33 ± 2.08 g–i | 8.00 ± 0.00 a,b | 29.00 ± 1.00 k | NA |
| M. luteus (ATCC381) | 26.33 ± 0.58 j | 31.00 ± 1.73 k | 10.33 ± 0.58 a–d | 12.07 ± 0.12 c–e | NA |
| E. faecalis (ATCC 29212) | 9.00 ± 1.00 a–d | 18.33 ± 1.15 f | 7.67 ± 1.15 a,b | 21.00 ± 2.64 g | NA |
| Microorganism | Essential Oils (mg/mL) | Positive Control (µg/mL) | |||
|---|---|---|---|---|---|
| Antimicrobial Activity | S. aromaticum | T. leptobotrys | L. nobilis | Ciprofloxacin | |
| Gram-negative bacteria | |||||
| E. coli (ATCC 35214) | MIC | 1.25 ± 0.00 b | 0.312 ± 0.00 a | 10.00 ± 0.00 e | 0.43 ± 0.00 |
| MMC | 2.50 ± 0.00 χ | 0.312 ± 0.00 α | 20.00 ± 0.00 φ | 0.43 ± 0.00 | |
| E. coli (ATCC 8739) | MIC | 5.00 ± 0.00 d | 2.50 ± 0.00 c | 80.00 ± 0.00 h | 0.85 ± 0.00 |
| MMC | 5.00 ± 0.00 δ | 2.50 ± 0.00 χ | 80.00 ± 0.00 η | 0.85 ± 0.00 | |
| K. pneumoniae (CIP 104727) | MIC | 1.25 ± 0.00 b | 0.625 ± 0.00 a | 20.00 ± 0.00 f | 0.85 ± 0.00 |
| MMC | 2.50 ± 0.00 χ | 0.625 ± 0.00 α | 40.00 ± 0.00 γ | 0.85 ± 0.00 | |
| K. pneumoniae (clinical isolates) | MIC | 2.50 ± 0.00 c | 2.50 ± 0.00 c | 20.00 ± 0.00 f | 225.00 ± 0.00 |
| MMC | 2.50 ± 0.00 χ | 2.50 ± 0.00 χ | 20.00 ± 0.00 φ | 225.00 ± 0.00 | |
| L. monocytogenes (ATCC 19115) | MIC | 1.25 ± 0.00 b | 0.312 ± 0.00 a | 20.00 ± 0.00 f | 14.06 ± 0.00 |
| MMC | 2.50 ± 0.00 χ | 0.312 ± 0.00 α | 40.00 ± 0.00 γ | 14.06 ± 0.00 | |
| S. enteritidis (DMB 560) | MIC | 1.25 ± 0.00 b | 0.625 ± 0.00 a | 20.00 ± 0.00 f | 14.06 ± 0.00 |
| MMC | 2.50 ± 0.00 χ | 0.625 ± 0.00 α | 40.00 ± 0.00 γ | 14.06 ± 0.00 | |
| P. aeruginosa (ATCC 27853) | MIC | 1.25 ± 0.00 b | 0.625 ± 0.00 a | 20.00 ± 0.00 f | 3.51 ± 0.00 |
| MMC | 2.50 ± 0.00 χ | 0.625 ± 0.00 α | 20.00 ± 0.00 φ | 3.51 ± 0.00 | |
| P. aeruginosa (DSM 50090) | MIC | 80.00 ± 0.00 h | 80.00 ± 0.00 h | 80.00 ± 0.00 h | 28.12 ± 0.00 |
| MMC | 80.00 ± 0.00 η | 80.00 ± 0.00 η | 80.00 ± 0.00 η | 28.12 ± 0.00 | |
| Gram-positive bacteria | |||||
| S. aureus (ATCC 29213) | MIC | 1.25 ± 0.00 b | 0.625 ± 0.00 a | 40.00 ± 0.00 g | 7.03 ± 0.00 |
| MMC | 1.25 ± 0.00 β | 0.625 ± 0.00 α | 40.00 ± 0.00 γ | 7.03 ± 0.00 | |
| S. aureus (209 PCIP 53156) | MIC | 5.00 ± 0.00 d | 1.25 ± 0.00 b | 20.00 ± 0.00 f | 225.00 ± 0.00 |
| MMC | 5.00 ± 0.00 δ | 1.25 ± 0.00 β | 20.00 ± 0.00 φ | 225.00 ± 0.00 | |
| B. cereus (ATCC 14579) | MIC | 1.25 ± 0.00 b | 0.312 ± 0.00 a | 10.00 ± 0.00 e | 0.85 ± 0.00 |
| MMC | 2.50 ± 0.00 χ | 0.312 ± 0.00 α | 10.00 ± 0.00 ε | 0.85 ± 0.00 | |
| M. luteus (ATCC381) | MIC | 5.00 ± 0.00 d | 2.50 ± 0.00 c | 10.00 ± 0.00 e | 225.00 ± 0.00 |
| MMC | 5.00 ± 0.00 δ | 2.50 ± 0.00 χ | 10.00 ± 0.00 ε | 225.00 ± 0.00 | |
| E. faecalis (ATCC 29212) | MIC | 1.25 ± 0.00 b | 0.625 ± 0.00 a | 40.00 ± 0.00 g | 0.43 ± 0.00 |
| MMC | 2.50 ± 0.00 χ | 0.625 ± 0.00 α | 40.00 ± 0.00 γ | 0.43 ± 0.00 | |
Publisher’s Note: MDPI stays neutral with regard to jurisdictional claims in published maps and institutional affiliations. |
© 2022 by the authors. Licensee MDPI, Basel, Switzerland. This article is an open access article distributed under the terms and conditions of the Creative Commons Attribution (CC BY) license (https://creativecommons.org/licenses/by/4.0/).
Share and Cite
Razzouk, S.; Mazri, M.A.; Jeldi, L.; Mnasri, B.; Ouahmane, L.; Alfeddy, M.N. Chemical Composition and Antimicrobial Activity of Essential Oils from Three Mediterranean Plants against Eighteen Pathogenic Bacteria and Fungi. Pharmaceutics 2022, 14, 1608. https://doi.org/10.3390/pharmaceutics14081608
Razzouk S, Mazri MA, Jeldi L, Mnasri B, Ouahmane L, Alfeddy MN. Chemical Composition and Antimicrobial Activity of Essential Oils from Three Mediterranean Plants against Eighteen Pathogenic Bacteria and Fungi. Pharmaceutics. 2022; 14(8):1608. https://doi.org/10.3390/pharmaceutics14081608
Chicago/Turabian StyleRazzouk, Soukaina, Mouaad Amine Mazri, Lamya Jeldi, Bacem Mnasri, Lahcen Ouahmane, and Mohamed Najib Alfeddy. 2022. "Chemical Composition and Antimicrobial Activity of Essential Oils from Three Mediterranean Plants against Eighteen Pathogenic Bacteria and Fungi" Pharmaceutics 14, no. 8: 1608. https://doi.org/10.3390/pharmaceutics14081608
APA StyleRazzouk, S., Mazri, M. A., Jeldi, L., Mnasri, B., Ouahmane, L., & Alfeddy, M. N. (2022). Chemical Composition and Antimicrobial Activity of Essential Oils from Three Mediterranean Plants against Eighteen Pathogenic Bacteria and Fungi. Pharmaceutics, 14(8), 1608. https://doi.org/10.3390/pharmaceutics14081608

